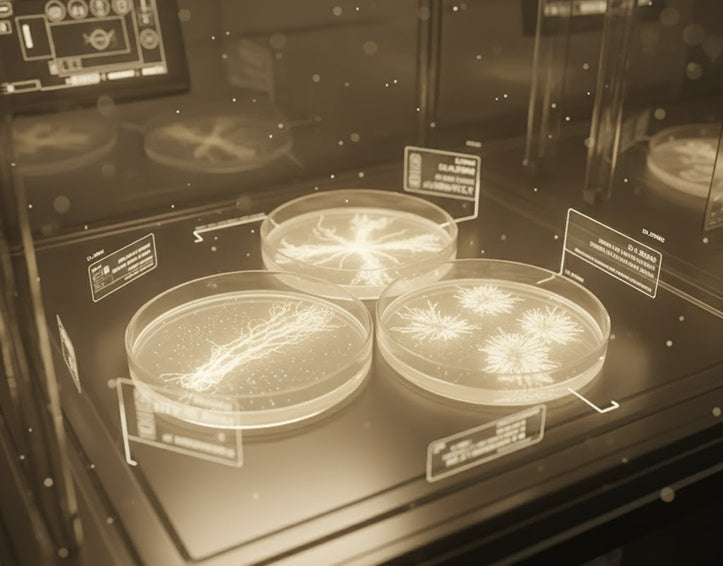

The Bien-Etre Cycle of Optimisation
-

Test Your NAD⁺ Levels
Discover your baseline and see how your cells produce energy and repair. -

Personalised Plan
Receive a targeted protocol based on your scores and goals. -

Supplement & Support
Follow your NuVivant NAD⁺ Booster plan to replenish and restore.
-

Re-Test & Refine
Measure progress every 3 months and watch your biology evolve.
Know Where You Stand
Your NAD⁺ Cellular Health Test reveals the foundation of your energy and repair capacity. Understanding your starting point is the first step toward sustainable improvement.
Your Plan, Designed Around Your Biology
Every plan is unique — tailored to your results and goals.
Our NuVivant NAD⁺ Intracellular Support Supplement supports cellular energy and DNA repair while complementary nutrition and habit recommendations amplify results.
The Bien-Etre Cycle of Optimisation
-

Consistent Energy
Support cellular ATP production for steady vitality.
-

Sharper Focus
Optimise brain metabolism and mental clarity.
-

Faster Recovery
Enhance muscle and cell repair after stress or exercise.
-

Greater Resilience
Strengthen immunity and long-term well-being.

Where Science Meets Self-Optimisation
Our NAD⁺ Optimisation Plan is built on peer-reviewed research in mitochondrial health and sirtuin activation. Each formula and recommendation is overseen by our Scientific Advisory Board to ensure effectiveness and safety.
The Bien-Etre NAD⁺ Intracellular Optimisation Plan
Includes
- Quarterly plans to fit your routine.
- Test kit + personalised NuVivant supplements + progress dashboard.
- Smarter, more personal wellness
- Re-test discounts and priority support.
Your Questions, Answered
How soon will I see results?
Most users notice improvements in energy and focus within 4–6 weeks; NAD⁺ levels typically rise within one testing cycle.
Is the programme safe?
All supplements are produced under GMP standards and tested for purity and potency.
Do I have to commit long-term?
No — you can choose monthly or quarterly plans and pause any time.
How do I track my progress?
Your dashboard stores results from each test so you can see your NAD⁺ trend improve over time.


